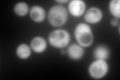
YEL046C
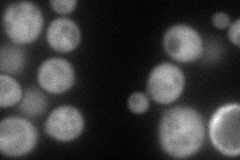
YEL046C
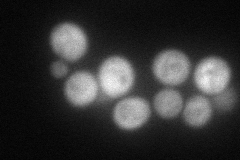
YEL046C
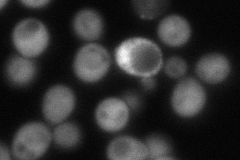
YEL046C
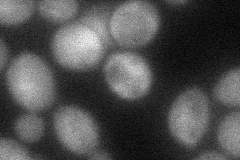
YEL046C
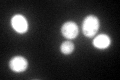
YEL046C

View description
Threonine aldolase, catalyzes the cleavage of L-allo-threonine and L-threonine to glycine; involved in glycine biosynthesis
Localization:
Intensity:
Fold change:
Significance:
-
C’ GFP library in SD
cytosol798.47 -
N' NOP1pr-GFP in SD
cytosol101.837 -
N' TEF2pr-mCherry in SD
cytosol101.912 -
N' NATIVEpr-GFP in SD
cytosol139.982 -
N' TEF2pr-VC and Cyto-VN in SD
cytosol45.3977 -
C’ GFP library in SD+DTT

cytosol770.220.96No -
C’ GFP library in SD+H2O2

cytosol827.51.03No -
C’ GFP library in Starvation Media
cytosol310.570.38Yes -
C’ GFP library on the background of Pup2-DaMP

cytosol -
C’ GFP library on the background of CCT mutant

cytosol762.9430.955495No
